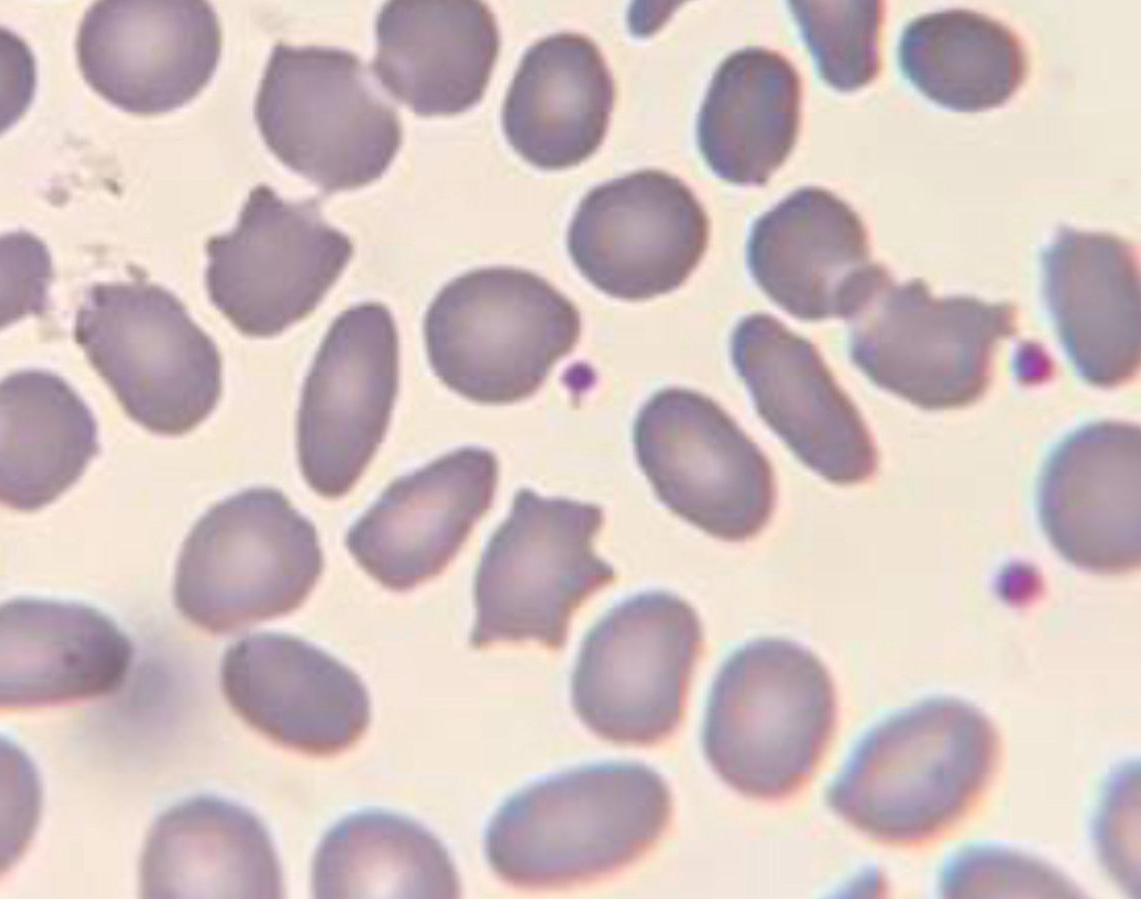

A relação entre acantócitos e colesterol diminuído em neoplasias
A integração entre a bioquímica e a hematologia representa uma das áreas mais instigantes da medicina laboratorial, pois permite compreender de forma abrangente como alterações metabólicas podem se refletir diretamente na morfologia celular. Nesse sentido, a presença de acantócitos em lâminas de hemograma surge como um marcador morfológico de grande relevância.
I
Presença de acantócitos em lâmina.
Como acontece a formação dos acantócitos
Em primeiro lugar, é necessário compreender que as células neoplásicas apresentam elevado consumo de nutrientes para sustentar sua rápida proliferação, incluindo o colesterol. Como o colesterol exerce papel estrutural fundamental na composição da membrana plasmática, garantindo fluidez, resistência e integridade celular, sua diminuição afeta diretamente a estabilidade eritrocitária. Dessa forma, quando os níveis séricos de colesterol encontram-se reduzidos em virtude do metabolismo tumoral, as hemácias passam a sofrer alterações em sua membrana, perdendo a regularidade da superfície e, consequentemente, formando projeções irregulares que caracterizam os acantócitos.
Além disso, é importante destacar que a correlação entre bioquímica e hematologia torna-se evidente à medida que a simples identificação de acantócitos em uma lâmina pode servir como indício indireto de alterações metabólicas relevantes. Desse modo, o hemograma, muitas vezes considerado um exame básico, amplia seu valor diagnóstico quando interpretado em conjunto com a dosagem bioquímica do colesterol. Assim, essa abordagem integrada permite não apenas sugerir a presença de distúrbios metabólicos relacionados ao câncer, mas também reforçar a importância de análises complementares para a elucidação clínica.

Como interpretar a presença de acantócitos no hemograma?
Convém salientar que a presença de acantócitos não deve ser interpretada de forma isolada, uma vez que sua ocorrência depende de múltiplos fatores. Por essa razão, o profissional de laboratório precisa considerar não só os achados morfológicos, mas também os dados clínicos, o histórico do paciente e outros exames bioquímicos. Portanto, ao integrar essas informações, consolida-se uma interpretação mais robusta e direcionada. Em virtude disso, o raciocínio crítico passa a ser o diferencial do analista que busca compreender as interações entre sistemas biológicos e entregar resultados que efetivamente impactam a conduta médica.
Conclusão
Diante do exposto, conclui-se que a relação entre a diminuição do colesterol e a formação de acantócitos em pacientes com câncer evidencia de maneira clara a força da integração entre a bioquímica e a hematologia. Desse modo, reconhecer e explorar esses vínculos não apenas aprimora a prática laboratorial, como também amplia a capacidade diagnóstica em contextos clínicos complexos.
Pós-Graduação em Bioquímica Clínica Avançada: Explore novos horizontes na sua carreira
Se você é um profissional dedicado na área da saúde em busca de aprimoramento e deseja desenvolver habilidades especializadas, senso crítico e expertise em Bioquímica Clínica, apresentamos a nossa Pós-Graduação como a escolha ideal para impulsionar sua carreira.
Desenvolvido meticulosamente para capacitar e atualizar profissionais como você, nosso programa altamente especializado oferece conhecimentos avançados que não apenas enriquecerão sua base de habilidades, mas também o destacarão no competitivo cenário profissional.
Oferecemos uma opção conveniente para quem busca uma pós-graduação 100% online e ao vivo, sem comprometer a excelência no ensino.
Nossa metodologia integra teoria e prática da rotina laboratorial, assegurando um aprendizado efetivo e aplicável.
Contamos com um corpo docente altamente qualificado, composto pelos melhores professores do Brasil, verdadeiras referências em suas respectivas áreas de atuação.
No Instituto Nacional de Medicina Laboratorial, nosso compromisso é singular: mais do que apenas transmitir conhecimento, buscamos transformar VOCÊ em uma referência.
Toque no botão abaixo e descubra mais sobre a Pós-Graduação em Bioquímica Clínica Avançada.
Sua jornada de excelência começa aqui.
QUERO CONHECER TODOS OS DETALHES DA PÓS-GRADUAÇÃO
Referências:
- Hoffbrand, A. V., Moss, P. A. H. Essential Haematology. 7th ed. Wiley-Blackwell, 2016.
- Burtis, C. A., Bruns, D. E. Tietz Fundamentals of Clinical Chemistry and Molecular Diagnostics. 8th ed. Elsevier, 2019.
- Lippi, G., Plebani, M. Hematology and Clinical Chemistry: Interference and Integration. Clin Biochem, v. 46, n. 7-8, p. 646–651, 2013.



